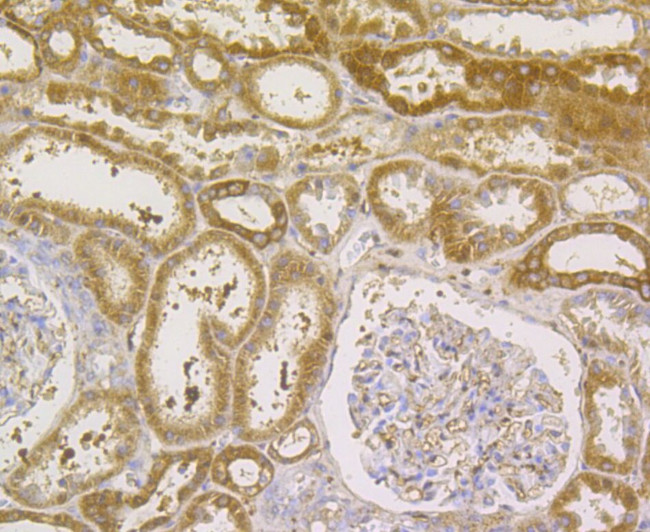
GPX1 Antibody in Immunohistochemistry (Paraffin) (IHC (P))

Search
Invitrogen
GPX1 Monoclonal Antibody (A6-C0-B9)
{{$productOrderCtrl.translations['antibody.pdp.commerceCard.promotion.promotions']}}
{{$productOrderCtrl.translations['antibody.pdp.commerceCard.promotion.viewpromo']}}
{{$productOrderCtrl.translations['antibody.pdp.commerceCard.promotion.promocode']}}: {{promo.promoCode}} {{promo.promoTitle}} {{promo.promoDescription}}. {{$productOrderCtrl.translations['antibody.pdp.commerceCard.promotion.learnmore']}}





Please note: We are reviewing Western blot images included in the antibody testing data in our catalog, including those provided by third parties. Unless expressly labeled or annotated as “raw-unedited”, Western blot images included in the antibody testing data in our catalog may have been edited, optimized or otherwise adjusted for presentation.
产品信息
MA5-34920
种属反应
宿主/亚型
分类
类型
克隆号
抗原
偶联物
形式
浓度
规格
纯化类型
保存液
内含物
保存条件
运输条件
RRID
产品详细信息
Positive Control: THP-1, human liver tissue, human kidney tissue, HepG2.
靶标信息
Glutathione peroxidases (Gpxs) are ubiquitously expressed proteins which catalyze the reduction of hydrogen peroxides and organic hydroperoxides by glutathione. There are several isoforms which differ in their primary structure and localization. The classical cytosolic/mitochondrial GPx1 (cGPx) is a selenium-dependent enzyme, first of the GPx family to be discovered. GPx2, also known as gastrointestinal GPx (GI-GPx), is an intracellular enzyme expressed only at the epithelium of the gastrointestinal tract. Extracellular plasma GPx (pGPx or GPx3) is mainly expressed by the kidney from where it is released into the blood circulation. Phospholipid hydroperoxide GPx4 (PH-GPx) expressed in most tissues, can reduce many hydroperoxides including hydroperoxides integrated in membranes, hydroperoxy lipids in low density lipoprotein or thymine. All mammalian GPx family members, except for the recently described Cys containing GPx3 and epididymis-specific secretory GPx (eGPx or GPx5) isoforms, possess selenocysteine at the active site.
仅用于科研。不用于诊断过程。未经明确授权不得转售。
篇参考文献 (0)
生物信息学
蛋白别名: Cellular glutathione peroxidase; Glutathione peroxidase 1; GPx-1; HGNC:4553; MGC14399; MGC88245; OTTHUMP00000210766; Phospholipid-hydroperoxide glutathione peroxidase GPX1
基因别名: GPX1
Entrez Gene ID: (Human) 2876